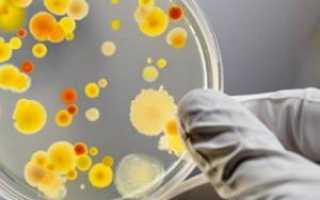

Энтеровирусная инфекция — группа вирусных заболеваний, преимущественно поражающих детей и вызывающих разнообразные симптомы, от легких до тяжелых. Знание признаков инфекции поможет своевременно обратиться за медицинской помощью и предотвратить осложнения. В статье рассмотрим основные проявления энтеровирусной инфекции у детей, методы диагностики и лечения, а также рекомендации по профилактике, что поможет родителям быть более подготовленными.
Причины возникновения
Энтеровирусы способны долго сохраняться в окружающей среде, находясь в почве, воде и продуктах питания, что объясняет их попадание в организм человека. Достаточно съесть зараженный фрукт или выпить испорченную воду, чтобы заразиться. Инкубационный период варьируется в зависимости от иммунной системы человека, но чаще всего не превышает десяти дней, после чего заболевание начинает проявляться, и появляются первые симптомы.
Заболевший становится носителем вируса и может заразить других людей как при непосредственном контакте, так и через воздух. Если инфекция затрагивает беременную женщину, существует риск передачи вируса ребенку.
Врачи отмечают, что у детей энтеровирусная инфекция может проявляться различными симптомами, такими как высокая температура, головная боль, боли в горле и животе, а также сыпь. Важно учитывать, что в некоторых случаях болезнь может протекать без явных симптомов или с минимальными проявлениями, что затрудняет диагностику. Специалисты подчеркивают, что основное лечение направлено на облегчение симптомов, так как специфических противовирусных средств не существует. Рекомендуется обильное питье, соблюдение постельного режима и применение жаропонижающих препаратов при высокой температуре. Врачи также советуют внимательно следить за состоянием ребенка и при ухудшении симптомов обращаться за медицинской помощью, чтобы избежать возможных осложнений. Профилактика, включая соблюдение гигиенических норм и вакцинацию, играет важную роль в снижении риска заражения.
Эксперты отмечают, что энтеровирусная инфекция у детей проявляется разнообразными симптомами, включая лихорадку, головную боль, боли в горле и сыпь. Важно помнить, что инфекция может протекать в легкой форме, но в некоторых случаях может вызывать более серьезные осложнения, такие как менингит или миокардит. Врачи рекомендуют родителям внимательно следить за состоянием ребенка и при появлении тревожных симптомов обращаться за медицинской помощью. Лечение в основном симптоматическое: необходимо обеспечить ребенку достаточное количество жидкости, контролировать температуру и при необходимости использовать жаропонижающие средства. Профилактика включает в себя соблюдение гигиенических норм и вакцинацию против других инфекций, что может снизить риск заражения.

Симптомы энтеровирусной инфекции у детей
У взрослых и детей проявления энтеровирусной инфекции разнообразны, так как инфекция способна проникнуть во все ткани и органы человека, в том числе и мозг.
Симптомы зависят не только от вида вируса, но и от иммунитета человека. Так, один зараженный может практически не почувствовать себя больным, когда другой человек с тем же типом вируса сляжет на несколько дней.
В большинстве случаев энтеровирусы проявляют себя респираторной формой. Для нее характерны симптомы обычной простуды с заложенностью носа, больным горлом и редким кашлем. (см. симптомы и лечение ОРВИ ).
Кишечная форма
заболевания также распространена. Для нее характерны такие проявления, как частая диарея, боли в желудке, метеоризм и симптомы умеренной интоксикации организма. Состояние больного осложнится, если к кишечной форме заболевания добавятся симптомы респираторной формы. Сочетание нескольких форм заболевания в большинстве случаев встречается у детей, но также возможно и у взрослых.
Лихорадка на фоне энтеровирусных инфекций возникает в рамках отдельной формы заболевания. Человек в таком случае не чувствует проявлений каких-либо других значимых симптомов. Температура обычно держится несколько дней, но самочувствие человека не сильно от этого ухудшается.
Иногда энтеровирусы проявляют себя герпетической ангиной. На слизистой ротовой полости появляются красные папулы, которые через несколько дней вскрываются, превращаясь в эрозированные участки. Проходит такая ангина примерно через неделю, в течение которой человека могут беспокоить не только папулы, но и незначительные боли в горле, а также увеличенные подчелюстные лимфоузлы.
Еще одним поверхностным выражением энтеровирусной инфекции является «бостонская лихорадка», для которой характерны высыпания на лице, туловище и конечностях. Сыпь держится около четырех дней. В этой форме заболевания человек страдает не только от сыпи, но и от лихорадки, которая обычно длится неделю. Кроме того, появляются общие симптомы интоксикации организма.
Крайне неприятной формой вируса является эпидемическая миалгия. Также ее называют «чертова пляска» или грипп «дьявольский». Человека поражают острые боли режущего характера в груди или животе, которые длятся около десяти минут с периодичностью в час. Боли продолжаются до 2 суток, сильно обессиливая человека. Высокая температура может держаться несколько дней. Но у половины заболевших отмечается вторая волна лихорадки с новыми приступами боли.
Помимо всего вышеперечисленного, энтеровирусные инфекции могут стать причиной развития менингита, энцефалита, полирадикулоневрита, миокардита, поражения почек и т. д.
| Симптом | Возможная тяжесть | Лечение/Рекомендации |
|---|---|---|
| Лихорадка | От легкой до высокой (более 39°C) | Постельный режим, обильное питье, жаропонижающие средства (парацетамол, ибупрофен) по назначению врача |
| Насморк | Легкий, умеренный, обильный | Симптоматическое лечение (солевые растворы для промывания носа) |
| Кашель | Сухой, влажный, различной интенсивности | Симптоматическое лечение (противокашлевые средства по назначению врача) |
| Боль в горле | Легкая, умеренная, сильная | Полоскание горла, обезболивающие пастилки/спреи по назначению врача |
| Рвота | От единичных эпизодов до многократной | Соблюдение диеты, регидратация (по назначению врача) |
| Диарея | От легкой до тяжелой, с обезвоживанием | Регидратация (оральные регидратационные растворы, внутривенное введение жидкости при тяжелом обезвоживании), диета |
| Высыпания на коже | Различные по характеру и локализации (пятнистые, папулезные, везикулезные) | Симптоматическое лечение (антигистаминные препараты по назначению врача) |
| Слабость, утомляемость | Легкая, умеренная, выраженная | Постельный режим, полноценный отдых |
| Боль в животе | Легкая, умеренная, сильная | Спазмолитики по назначению врача |
| Менингеальные симптомы (ригидность затылочных мышц, головная боль) | От легких до выраженных | Госпитализация, противовирусная терапия (в тяжелых случаях), симптоматическое лечение |
| Обезвоживание | Различной степени тяжести | Регидратация (оральные регидратационные растворы, внутривенное введение жидкости) |
Интересные факты
Вот несколько интересных фактов об энтеровирусной инфекции, особенно в контексте детей:
-
Широкий спектр симптомов: Энтеровирусы могут вызывать разнообразные симптомы, которые варьируются от легких респираторных проявлений до более серьезных состояний, таких как менингит или миокардит. У детей часто наблюдаются такие симптомы, как высокая температура, сыпь, боли в горле и животе, а также усталость.
-
Передача и распространение: Энтеровирусы передаются преимущественно фекально-оральным путем, а также через прямой контакт с инфицированными людьми или поверхностями. Это делает их особенно распространенными в детских коллективах, таких как детские сады и школы, где дети могут не соблюдать правила гигиены.
-
Лечение и профилактика: Специфического противовирусного лечения для энтеровирусной инфекции не существует. Лечение обычно симптоматическое и направлено на облегчение состояния пациента. Вакцины против некоторых типов энтеровирусов, таких как полиомиелит, существуют, но для большинства энтеровирусов вакцинация не разработана, что подчеркивает важность соблюдения гигиенических мер для предотвращения инфекции.

Лечение энтеровирусной инфекции
Учитывая широкий спектр клинических проявлений энтеровирусной инфекции, невозможно установить диагноз только на основе внешних симптомов у детей или взрослых.
Для диагностики энтеровирусов применяются следующие методы:
- Серологический. Этот метод направлен на обнаружение вирусных маркеров в крови пациента.
- Вирусологический. Он включает выделение вируса из образцов, которые могут содержать инфекцию (кровь и другие биологические жидкости).
- Молекулярно-биологический. Этот метод позволяет выявить генетический материал (фрагменты РНК) вируса.
При положительных результатах анализов необходимо назначить соответствующее лечение. В терапии энтеровирусов применяются препараты альфа-интерферонов, которые эффективно защищают здоровые клетки организма. Если инфекция развивается на фоне иммунодефицита, в лечении используются иммуноглобулины.
Также важна симптоматическая терапия, направленная на устранение неприятных проявлений заболевания. Например, при высокой температуре целесообразно назначение жаропонижающих средств. При частой рвоте могут потребоваться противорвотные препараты, а также меры для предотвращения обезвоживания. Если к заболеванию присоединяется вторичная инфекция, необходимо лечение антибиотиками широкого спектра действия. При наличии болей назначаются обезболивающие средства.
Выбор схемы симптоматического лечения зависит от формы заболевания. В случае кишечной формы необходимо дополнительно соблюдать диету, которая поможет восстановить состояние пациента после рвоты или диареи. Пища должна быть легкоусвояемой и не раздражать слизистую желудка и кишечника. Следует избегать газированных напитков, сладостей, острых, соленых и жареных блюд. Диета №4 является подходящей для пациентов с кишечной формой энтеровирусной инфекции.
Кроме того, во время лечения пациент должен находиться под наблюдением врачей в стационаре, так как энтеровирусные инфекции очень заразны. Члены семьи и лица, контактировавшие с больным до и после появления симптомов, также должны пройти обследование на наличие инфекции, чтобы предотвратить массовые вспышки заболевания.
Энтеровирусная инфекция вызывает значительное беспокойство у родителей, особенно когда речь идет о детях. Симптомы могут варьироваться от легких до тяжелых и часто включают лихорадку, головную боль, боль в горле и сыпь. Некоторые дети могут испытывать боли в животе и диарею. Важно помнить, что большинство случаев проходит самостоятельно, и лечение в основном симптоматическое: жаропонижающие средства и обильное питье. Однако в редких случаях инфекция может привести к более серьезным осложнениям, таким как менингит. Родителям следует внимательно следить за состоянием ребенка и при ухудшении симптомов обращаться к врачу. Профилактика включает соблюдение гигиенических норм и избегание контакта с больными.
Профилактика энтеровирусной инфекции
К сожалению, специфических мероприятий, которые позволят защититься от энтеровирусов на 100%, не существует. Взрослые или дети могут выполнять те защитные действия, которые лишь теоретически не позволят вирусам попасть в организм.
Таким образом, профилактические мероприятия сводятся к следованию общим правилам личной гигиены. Необходимо тщательно мыть руки после посещения уборной, а также перед каждым приемом пищи. Если возможности вымыть руки нет, то следует воспользоваться гигиеническим гелем для рук, который можно приобрести в любом аптечном пункте. Также стоит серьезно относиться к обработке фруктов и овощей, так как вирус может долгое время находиться во внешней среде.
В случае заболевания члена семьи, нужно продезинфицировать посуду, которой пользовался больной, и тщательно постирать его личные вещи. Помимо этого, в доме стоит часто проветривать и провести влажную уборку помещений.
При массовых вспышках заболевания детям показаны лейкоцитарный интерферон и иммуноглобулин в малых дозах в качестве защиты от инфицирования, а взрослым стоит избегать скопления людей.

Осложнения заболевания
Энтеровирусные инфекции способны затрагивать все органы и ткани человеческого организма, что и объясняет разнообразие клинических проявлений этих заболеваний. В большинстве случаев люди переносят инфекцию без серьезных последствий. Однако в некоторых ситуациях, особенно при ослабленном иммунитете или наличии сопутствующих заболеваний, могут возникать осложнения, такие как менингит и энцефалит.
Оба этих состояния затрагивают головной мозг, что может привести к следующим последствиям:
- общей слабости и повышенной утомляемости;
- повышению артериального давления;
- параличу;
- развитию эпилептических приступов;
- летальному исходу.
Также существует риск присоединения вторичной инфекции, что потребует дополнительных мер лечения. Смертельные исходы чаще всего связаны с острой сердечной или легочной недостаточностью, которые могут возникнуть из-за самолечения или запоздалого обращения за квалифицированной медицинской помощью.
Каковы основные симптомы энтеровирусной инфекции у детей?
Основные симптомы энтеровирусной инфекции у детей включают высокую температуру, головную боль, боль в горле, сыпь, а также симптомы со стороны желудочно-кишечного тракта, такие как рвота и диарея. В некоторых случаях может наблюдаться и воспаление мозговых оболочек, что проявляется в виде менингита.
Как проводится лечение энтеровирусной инфекции у детей?
Терапия энтеровирусной инфекции в основном направлена на облегчение симптомов. Ключевым моментом является обеспечение ребенка достаточным объемом жидкости, чтобы избежать обезвоживания, а также применение жаропонижающих препаратов при повышенной температуре. В большинстве ситуаций инфекция проходит без вмешательства, однако в тяжелых случаях может понадобиться госпитализация и специализированная медицинская помощь.
Как можно предотвратить заражение энтеровирусной инфекцией?
Для предотвращения заражения энтеровирусной инфекцией рекомендуется соблюдать правила личной гигиены, такие как регулярное мытье рук с мылом, особенно после посещения общественных мест. Также следует избегать контакта с больными людьми и соблюдать меры предосторожности во время вспышек инфекции.
Диагностика энтеровирусной инфекции
Диагностика энтеровирусной инфекции представляет собой важный этап в определении наличия заболевания и назначения соответствующего лечения. Основные методы диагностики включают клинический осмотр, лабораторные исследования и, в некоторых случаях, инструментальные методы.
Первоначально врач проводит клинический осмотр, во время которого оцениваются симптомы, проявляющиеся у ребенка. К ним могут относиться высокая температура, сыпь, боли в горле, головная боль, мышечные боли и другие признаки, характерные для вирусной инфекции. Важно также собрать анамнез, выяснив, были ли у ребенка контакты с больными людьми или посещение мест с высокой заболеваемостью.
Для подтверждения диагноза используются лабораторные исследования. Одним из наиболее информативных методов является ПЦР (полимеразная цепная реакция), которая позволяет выявить генетический материал вируса в образцах, таких как мазки из горла, образцы кала или ликвор. ПЦР-тесты обладают высокой чувствительностью и специфичностью, что делает их основным методом диагностики энтеровирусной инфекции.
Также могут быть проведены серологические исследования, которые определяют наличие антител к энтеровирусам в крови. Однако этот метод менее информативен на ранних стадиях заболевания, так как антитела начинают вырабатываться только через несколько дней после заражения.
В некоторых случаях, особенно при тяжелом течении болезни или подозрении на менингит, может потребоваться люмбальная пункция для анализа спинномозговой жидкости. Это исследование позволяет оценить наличие вируса и воспалительных изменений в центральной нервной системе.
Важно отметить, что диагностика энтеровирусной инфекции может быть затруднена из-за схожести симптомов с другими вирусными заболеваниями, такими как грипп или аденовирусная инфекция. Поэтому для точного диагноза может потребоваться комплексный подход, включающий как клинические, так и лабораторные методы.
В заключение, диагностика энтеровирусной инфекции требует внимательного подхода и использования современных методов, что позволяет своевременно выявить заболевание и начать необходимое лечение, минимизируя риск осложнений.
Вопрос-ответ
Какие основные симптомы энтеровирусной инфекции у детей?
Основные симптомы энтеровирусной инфекции у детей могут включать высокую температуру, головную боль, боли в горле, сыпь, а также симптомы со стороны желудочно-кишечного тракта, такие как рвота и диарея. В некоторых случаях могут наблюдаться также мышечные боли и общая слабость.
Лечение энтеровирусной инфекции в основном симптоматическое. Важно обеспечить ребенку достаточное количество жидкости, чтобы избежать обезвоживания. При необходимости могут быть назначены жаропонижающие средства и препараты для облегчения болей. В большинстве случаев инфекция проходит самостоятельно, и специфическое лечение не требуется.
Как можно предотвратить заражение энтеровирусом у детей?
Для предотвращения заражения энтеровирусом важно соблюдать правила личной гигиены: регулярно мыть руки с мылом, особенно после посещения общественных мест и перед едой. Также стоит избегать контакта с больными людьми и следить за чистотой игрушек и предметов, с которыми играет ребенок.
Советы
СОВЕТ №1
Обратите внимание на симптомы: при первых признаках энтеровирусной инфекции, таких как высокая температура, сыпь или боли в животе, немедленно обратитесь к врачу. Раннее выявление заболевания поможет избежать осложнений.
СОВЕТ №2
Следите за гигиеной: регулярное мытье рук и использование антисептиков помогут предотвратить распространение вируса. Обучите детей правильным гигиеническим привычкам, особенно после посещения общественных мест.
СОВЕТ №3
Обеспечьте достаточное питье: при энтеровирусной инфекции важно поддерживать водный баланс. Убедитесь, что ваш ребенок пьет достаточно жидкости, чтобы избежать обезвоживания, особенно если у него наблюдаются рвота или диарея.
СОВЕТ №4
Не занимайтесь самолечением: избегайте использования антибиотиков без назначения врача, так как они неэффективны против вирусов. Следуйте рекомендациям специалиста по лечению и уходу за ребенком.